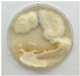
Biomolecules 12 00097 i003
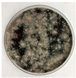
Biomolecules 12 00097 i004
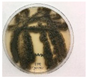
Biomolecules 12 00097 i006

Volatile Emissions and Relative Attraction of the Fungal Symbionts of Tea Shot Hole Borer (Coleoptera: Curculionidae) †
Abstract
:1. Introduction
2. Materials and Methods
2.1. Fungal Cultures
2.2. Test Chemicals
2.3. Volatile Extraction
2.4. Gas Chromatography–Mass Spectrometry Analysis
2.5. Collection and Quantification of p-Menth-2-en-1-ols
2.6. Experimental Insects
2.7. Laboratory Bioassays
2.8. Statistical Analysis
3. Results and Discussion
3.1. Volatile Emissions of Symbionts
3.2. cis- and trans-p-Menth-2-en-1-ol Emissions from Graphium sp.
3.3. Laboratory Bioassays
4. Conclusions
Author Contributions
Funding
Institutional Review Board Statement
Informed Consent Statement
Data Availability Statement
Acknowledgments
Conflicts of Interest
References
- Smith, S.M.; Gomez, D.F.; Beaver, R.A.; Hulcr, J.; Cognato, A.I. Reassessment of the species in the Euwallacea fornicatus (Coleoptera: Curculionidae: Scolytinae) complex after the rediscovery of the ‘lost’ type specimen. Insects 2019, 10, 261. [Google Scholar] [CrossRef] [PubMed] [Green Version]
- Hulcr, J.; Stelinski, L.L. The ambrosia symbiosis: From evolutionary ecology to practical management. Ann. Rev. Entomol. 2017, 62, 285–303. [Google Scholar] [CrossRef] [PubMed] [Green Version]
- Eskalen, A.; Stouthamer, R.; Lynch, S.C.; Rugman-Jones, P.F.; Twizeyimana, M.; Gonzalez, A.; Thiboult, T. Host range of Fusarium dieback and its ambrosia beetle (Coleoptera: Scolytinae) vector in southern California. Plant Dis. 2013, 97, 938–951. [Google Scholar] [CrossRef] [Green Version]
- Carrillo, D.; Cruz, L.F.; Kendra, P.E.; Narvaez, T.I.; Montgomery, W.S.; Monterroso, A.; DeGrave, C.; Cooperband, M.R. Distribution, pest status, and fungal associates of Euwallacea nr. fornicatus in Florida avocado groves. Insects 2016, 7, 55. [Google Scholar] [CrossRef]
- Kendra, P.E.; Owens, D.; Montgomery, W.S.; Narvaez, T.I.; Bauchan, G.R.; Schnell, E.Q.; Tabanca, N.; Carrillo, D. α-Copaene is an attractant, synergistic with quercivorol, for improved detection of Euwallacea nr. fornicatus (Coleoptera: Curculionidae: Scolytinae). PLoS ONE 2017, 12, e0179416. [Google Scholar] [CrossRef]
- Danthanarayana, W. The distribution and host-range of the shot-hole borer (Xyleborus fornicatus Eichh.) of tea. Tea Quart. 1968, 39, 61–69. [Google Scholar]
- Owens, D.; Cruz, L.F.; Montgomery, W.S.; Narvaez, T.I.; Schnell, E.Q.; Tabanca, N.; Duncan, R.E.; Carrillo, D.; Kendra, P.E. Host range expansion and increasing damage potential of Euwallacea nr. fornicatus (Coleoptera: Curculionidae) in Florida. Fla. Entomol. 2018, 101, 229–236. [Google Scholar] [CrossRef] [Green Version]
- United States Department of Agriculture, National Agricultural Statistics Service, Quick Stats. Available online: https://quickstats.nass.usda.gov/ (accessed on 13 December 2021).
- Kendra, P.E.; Montgomery, W.S.; Niogret, J.; Pruett, G.E.; Mayfield, A.E.; MacKenzie, M.; Deyrup, M.A.; Bauchan, G.R.; Ploetz, R.C.; Epsky, N.D. North American Lauraceae: Terpenoid emissions, relative attraction and boring preferences of redbay ambrosia beetle, Xyleborus glabratus (Coleoptera: Curculionidae: Scolytinae). PLoS ONE 2014, 9, e102086. [Google Scholar] [CrossRef]
- Ploetz, R.C.; Kendra, P.E.; Choudhury, R.A.; Rollins, J.A.; Campbell, A.; Garrett, K.; Hughes, M.; Dreaden, T. Laurel wilt in natural and agricultural ecosystems: Understanding the drivers and scales of complex pathosystems. Forests 2017, 8, 48. [Google Scholar] [CrossRef]
- Carrillo, D.; Duncan, R.E.; Ploetz, J.N.; Campbell, A.; Ploetz, R.C.; Peña, J.E. Lateral transfer of a phytopathogenic symbiont among native and exotic ambrosia beetles. Plant Pathol. 2014, 63, 54–62. [Google Scholar] [CrossRef]
- Ploetz, R.C.; Konkol, J.L.; Narvaez, T.; Duncan, R.E.; Saucedo, R.J.; Campbell, A.; Mantilla, J.; Carrillo, D.; Kendra, P.E. Presence and prevalence of Raffaelea lauricola, cause of laurel wilt, in different species of ambrosia beetle in Florida, USA. J. Econ. Entomol. 2017, 110, 347–354. [Google Scholar] [CrossRef] [PubMed]
- Carrillo, D.; Narvaez, T.; Cossé, A.A.; Stouthamer, R.; Cooperband, M. Attraction of Euwallacea nr. fornicatus (Coleoptera: Curculionidae: Scolytinae) to lures containing quercivorol. Fla. Entomol. 2015, 98, 780–782. [Google Scholar] [CrossRef]
- Kendra, P.E.; Montgomery, W.S.; Narvaez, T.I.; Carrillo, D. Comparison of trap designs for detection of Euwallacea nr. fornicatus and other Scolytinae (Coleoptera: Curculionidae) that vector fungal pathogens of avocado trees in Florida. J. Econ. Entomol. 2020, 113, 980–987. [Google Scholar] [CrossRef] [PubMed]
- Kendra, P.E.; Montgomery, W.S.; Deyrup, M.A.; Wakarchuk, D. Improved lure for redbay ambrosia beetle developed by enrichment of α-copaene content. J. Pest Sci. 2016, 89, 427–438. [Google Scholar] [CrossRef]
- Owens, D.; Kendra, P.E.; Tabanca, N.; Narvaez, T.I.; Montgomery, W.S.; Schnell, E.Q.; Carrillo, D. Quantitative analysis of content and volatile emissions from α-copaene and quercivorol lures, and longevity for attraction of Euwallacea nr. fornicatus in Florida. J. Pest Sci. 2019, 92, 237–252. [Google Scholar] [CrossRef]
- Owens, D.; Seo, M.; Montgomery, W.S.; Rivera, M.J.; Stelinski, L.L.; Kendra, P.E. Dispersal behaviour of Euwallacea nr. fornicatus (Coleoptera: Curculionidae: Scolytinae) in avocado groves and estimation of lure sampling range. Agric. Forest Entomol. 2019, 21, 199–208. [Google Scholar] [CrossRef]
- Kashiwagi, T.; Nakashima, T.; Tebayashi, T.; Kim, C.S. Determination of the absolute configuration of quercivorol (1S,4R)-p-menth-2-en-1-ol, an aggregation pheromone of the ambrosia beetle Platypus quercivorus (Coleoptera: Platypodidae). Biosci. Biotechnol. Biochem. 2006, 70, 2544–2546. [Google Scholar] [CrossRef] [Green Version]
- Menocal, O.; Cruz, L.F.; Kendra, P.E.; Crane, J.H.; Ploetz, R.C.; Carrillo, D. Rearing Xyleborus volvulus (Coleoptera: Curculionidae) on media containing sawdust from avocado or silkbay, with or without Raffaelea lauricola (Ophiostomatales: Ophiostomataceae). Environ. Entomol. 2017, 46, 1275–1283. [Google Scholar] [CrossRef]
- Van Den Dool, H.; Kratz, P.D. A generalization of the retention index system including linear temperature programmed gas-liquid partition chromatography. J. Chromatogr. A 1963, 11, 463–471. [Google Scholar] [CrossRef]
- MassFinder. MassFinder Software, Version 3; Hochmuth Scientific Consulting: Hamburg, Germany, 2004. [Google Scholar]
- Adams, R.P. Identification of Essential Oil Components by Gas Chromatography/Mass Spectrometry, 4th ed.; Allured Publishing Corp: Carol Stream, IL, USA, 2017; pp. 1–804. [Google Scholar]
- FFNSC-3. Flavors and Fragrances of Natural and Synthetic Compounds 3. In Mass Spectral Database; Scientific Instrument Services Inc.: Hoboken, NJ, USA, 2015. [Google Scholar]
- Wiley Science Solutions. Wiley Registry 12th Edition/NIST 2020 Mass Spectral Library; Scientific Instrument Services Inc.: Ringoes, NJ, USA, 2020. [Google Scholar]
- Cruz, L.F.; Cruz, J.C.; Carrillo, D.; Mtz-Enriquez, A.I.; Lamelas, A.; Ibarra-Juarez, L.A.; Pariona, N. In-vitro evaluation of copper nanoparticles as a potential control agent against the fungal symbionts of the invasive ambrosia beetle Euwallacea fornicatus. Crop. Prot. 2021, 143, 105564. [Google Scholar] [CrossRef]
- Kendra, P.E.; Montgomery, W.S.; Niogret, J.; Peña, J.E.; Capinera, J.L.; Brar, G.; Epsky, N.D.; Heath, R.R. Attraction of the redbay ambrosia beetle, Xyleborus glabratus, to avocado, lychee and essential oil lures. J. Chem. Ecol. 2011, 37, 932–942. [Google Scholar] [CrossRef]
- Demyttenaere, J.C.; Adams, A.; Van Bellaghem, K.; De Kimpe, N.; Koenig, W.A.; Tkachev, A.V. De novo production of (+)-aristolocheme by sporulated surface cultures of Penicillium roqueforti. Phytochemistry 2002, 59, 597–602. [Google Scholar] [CrossRef]
- Dodge, C.; Coolidge, J.; Cooperband, M.; Cossé, A.; Carrillo, D.; Stouthamer, R. Quercivorol as a lure for the polyphagous and Kuroshio shot hole borers, Euwallacea spp. nr. fornicatus (Coleoptera: Scolytinae), vectors of Fusarium dieback. Peer J 2017, 5, e3656. [Google Scholar] [CrossRef] [PubMed] [Green Version]
- Miller, D.R.; Borden, J.H. β-Phellandrene: Kairomone for pine engraver Ips pini (Say) (Coleoptera: Scolytidae). J. Chem. Ecol. 1990, 16, 2519–2531. [Google Scholar] [CrossRef]
- Wimalaratne, P.D.C.; Slessor, K.N.; Borden, J.H. Isolation and identification of house fly, Musca domestica L., repellents from pepper tree, Schinus molle L. J. Chem. Ecol. 1996, 22, 49–59. [Google Scholar] [CrossRef] [Green Version]
- López, A.; Castro, S.; Andina, M.J.; Ures, X.; Munguía, B.; Llabot, J.M.; Elder, H.; Dellacassa, E.; Palma, S.; Domínguez, L. Insecticidal activity of microencapsulated Schinus molle essential oil. Ind. Crops. Prod. 2014, 53, 209–216. [Google Scholar] [CrossRef]
- Wang, Y.; Zhang, L.T.; Feng, Y.X.; Guo, S.S.; Pang, X.; Zhang, D.; Geng, Z.F.; Du, S.S. Insecticidal and repellent efficacy against stored-product insects of oxygenated monoterpenes and 2-dodecanone of the essential oil from Zanthoxylum planispinum var. dintanensis. Environ. Sci. Pollut. Res. Int. 2019, 26, 24988–24997. [Google Scholar] [CrossRef]
- Martini, X.; Hughes, M.A.; Smith, J.A.; Stelinski, L.L. Attraction of redbay ambrosia beetle, Xyleborus glabratus, to leaf volatiles of its host plants in North America. J. Chem. Ecol. 2015, 41, 613–621. [Google Scholar] [CrossRef]
- Rivera, M.J.; Martini, X.; Conover, D.; Mafra-Neto, A.; Carrillo, D.; Stelinski, L.L. Evaluation of semiochemical based push-pull strategy for population suppression of ambrosia beetle vectors of laurel wilt disease in avocado. Sci. Rep. 2020, 10, 2670. [Google Scholar] [CrossRef] [Green Version]
- Miller, D.R. Limonene: Attractant kairomone for white pine cone beetles (Coleoptera: Scolytidae) in an eastern white pine seed orchard in western North Carolina. J. Econ. Entomol. 2007, 100, 815–822. [Google Scholar] [CrossRef]
- Kendra, P.E.; Montgomery, W.S.; Niogret, J.; Deyrup, M.A.; Guillén, L.; Epsky, N.D. Xyleborus glabratus, X. affinis, and X. ferrugineus (Coleoptera: Curculionidae: Scolytinae): Electroantennal responses to host-based attractants and temporal patterns in host-seeking flight. Environ. Entomol. 2012, 41, 1597–1605. [Google Scholar] [CrossRef] [PubMed]






| # | Compounds | * RI Exp | ** RI Lit | Composition of Volatile Emissions (Relative % ± SE) | |||||
|---|---|---|---|---|---|---|---|---|---|
![]() | ![]() | ![]() | ![]() | ![]() | ![]() | ||||
| Acremonium murorum | Acremonium sp. | AF-6 | AF-8 | Fusarium sp. nov. | Graphium sp. | ||||
| 1 | α-phellandrene a | 1007 | 1002 | 9.63 ± 2.91 | 0.00 ± 0.00 | 0.00 ± 0.00 | 0.00 ± 0.00 | 0.00 ± 0.00 | 4.76 ± 1.33 |
| 2 | α-terpinene a | 1018 | 1014 | 2.45 ± 0.81 | 0.00 ± 0.00 | 0.00 ± 0.00 | 0.00 ± 0.00 | 0.00 ± 0.00 | 2.03 ± 0.69 |
| 3 | p-cymene a | 1026 | 1020 | 1.59 ± 10.67 | 0.00 ± 0.00 | 0.00 ± 0.00 | 0.00 ± 0.00 | 0.00 ± 0.00 | 0.87 ± 0.58 |
| 4 | Limonene a | 1029 | 1024 | 0.00 ± 0.00 | 31.81 ± 7.66 | 66.96 ± 3.54 | 0.00 ± 0.00 | 80.61 ± 6.76 | 0.00 ± 0.00 |
| 5 | β-phellandrene b | 1030 | 1025 | 12.06 ± 3.45 | 0.00 ± 0.00 | 0.00 ± 0.00 | 6.68 ± 1.59 | 0.00 ± 0.00 | 7.69 ± 2.13 |
| 6 | cis-p-menth-2-en-1-ol a | 1131 | 1118 | 0.71 ± 0.04 | 20.79 ± 5.25 | 0.00 ± 0.00 | 0.00 ± 0.00 | 0.00 ± 0.00 | 40.13 ± 4.00 |
| 7 | cis-p-mentha-2,8-dien-1-ol b | 1144 | 1133 | 2.16 ± 0.25 | 0.00 ± 0.00 | 0.00 ± 0.00 | 0.00 ± 0.00 | 0.00 ± 0.00 | 0.16 ± 0.04 |
| 8 | trans-p-menth-2-en-1-ol a | 1149 | 1136 | 71.40 ± 6.02 | 39.15 ± 6.36 | 20.38 ± 1.83 | 23.56 ± 4.36 | 19.39 ± 6.76 | 27.32 ± 2.96 |
| 9 | terpinen-4-ol a | 1185 | 1174 | 0.00 ± 0.00 | 0.00 ± 0.00 | 0.00 ± 0.00 | 0.00 ± 0.00 | 0.00 ± 0.00 | 1.92 ± 0.08 |
| 10 | α-terpineol a | 1199 | 1186 | 0.00 ± 0.00 | 0.00 ± 0.00 | 0.00 ± 0.00 | 0.00 ± 0.00 | 0.00 ± 0.00 | 0.68 ± 0.05 |
| 11 | trans-piperitol b | 1203 | 1207 | 0.00 ± 0.00 | 0.00 ± 0.00 | 0.00 ± 0.00 | 0.00 ± 0.00 | 0.00 ± 0.00 | 0.32 ± 0.04 |
| 12 | β-elemene a | 1394 | 1389 | 0.00 ± 0.00 | 0.00 ± 0.00 | 0.00 ± 0.00 | 0.00 ± 0.00 | 0.00 ± 0.00 | 0.50 ± 0.11 |
| 13 | Aristolochene b | 1486 | 1496 | 0.00 ± 0.00 | 8.25 ± 4.18 | 12.65 ± 2.00 | 49.43 ± 3.99 | 0.00 ± 0.00 | 10.21 ± 1.59 |
| 14 | Valencene a | 1494 | 1496 | 0.00 ± 0.00 | 0.00 ± 0.00 | 0.00 ± 0.00 | 20.32 ± 2.33 | 0.00 ± 0.00 | 1.14 ± 0.20 |
| 15 | β-bazzanene a | 1522 | 1519 | 0.00 ± 0.00 | 0.00 ± 0.00 | 0.00 ± 0.00 | 0.00 ± 0.00 | 0.00 ± 0.00 | 0.96 ± 0.18 |
| Total | 100.00 ± 0.00 | 100.00 ± 0.00 | 99.99 ± 0.00 | 99.99 ± 0.00 | 100.00 ± 0.00 | 98.69 ± 0.20 | |||
| Compound | F1 | F2 | F3 | F4 | F5 |
|---|---|---|---|---|---|
| 1 | 0.278 | 0.298 | −0.030 | −0.138 | 0.075 |
| 2 | 0.333 | 0.189 | −0.029 | −0.150 | 0.070 |
| 3 | 0.289 | 0.280 | −0.030 | −0.141 | 0.074 |
| 4 | −0.243 | −0.102 | −0.418 | −0.450 | −0.098 |
| 5 | 0.261 | 0.239 | 0.291 | −0.209 | −0.254 |
| 6 | 0.261 | −0.256 | −0.079 | 0.637 | −0.169 |
| 7 | 0.158 | 0.415 | −0.026 | −0.100 | 0.071 |
| 8 | 0.148 | 0.399 | −0.035 | 0.459 | −0.022 |
| 9 | 0.307 | −0.252 | −0.010 | −0.101 | 0.015 |
| 10 | 0.307 | −0.252 | −0.010 | −0.101 | 0.015 |
| 11 | 0.307 | −0.252 | −0.010 | −0.101 | 0.015 |
| 12 | 0.307 | −0.252 | −0.010 | −0.101 | 0.015 |
| 13 | −0.091 | −0.115 | 0.594 | −0.013 | 0.694 |
| 14 | −0.084 | −0.048 | 0.613 | −0.121 | −0.627 |
| 15 | 0.307 | −0.252 | −0.010 | −0.101 | 0.015 |
| Eigenvalue | 7.411 | 4.694 | 2.446 | 0.421 | 0.027 |
| % Variance | 49.407 | 31.296 | 16.309 | 2.809 | 0.179 |
Publisher’s Note: MDPI stays neutral with regard to jurisdictional claims in published maps and institutional affiliations. |
© 2022 by the US government employees and is in the public domain in the US. Licensee MDPI, Basel, Switzerland. This article is an open access article distributed under the terms and conditions of the Creative Commons Attribution (CC BY) license (https://creativecommons.org/licenses/by/4.0/).
Share and Cite
Kendra, P.E.; Tabanca, N.; Cruz, L.F.; Menocal, O.; Schnell, E.Q.; Carrillo, D. Volatile Emissions and Relative Attraction of the Fungal Symbionts of Tea Shot Hole Borer (Coleoptera: Curculionidae). Biomolecules 2022, 12, 97. https://doi.org/10.3390/biom12010097
Kendra PE, Tabanca N, Cruz LF, Menocal O, Schnell EQ, Carrillo D. Volatile Emissions and Relative Attraction of the Fungal Symbionts of Tea Shot Hole Borer (Coleoptera: Curculionidae). Biomolecules. 2022; 12(1):97. https://doi.org/10.3390/biom12010097
Chicago/Turabian StyleKendra, Paul E., Nurhayat Tabanca, Luisa F. Cruz, Octavio Menocal, Elena Q. Schnell, and Daniel Carrillo. 2022. "Volatile Emissions and Relative Attraction of the Fungal Symbionts of Tea Shot Hole Borer (Coleoptera: Curculionidae)" Biomolecules 12, no. 1: 97. https://doi.org/10.3390/biom12010097
APA StyleKendra, P. E., Tabanca, N., Cruz, L. F., Menocal, O., Schnell, E. Q., & Carrillo, D. (2022). Volatile Emissions and Relative Attraction of the Fungal Symbionts of Tea Shot Hole Borer (Coleoptera: Curculionidae). Biomolecules, 12(1), 97. https://doi.org/10.3390/biom12010097